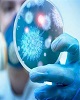
یک روز دیگر بدون مرگ و میر کرونا در کرمانشاه ثبت شد

سرپرست دانشگاه علوم پزشکی کرمانشاه :

سرپرست دانشگاه علوم پزشکی کرمانشاه گفت: پیک ششم کرونا در حال حاضر در استان آغاز شده است و تعداد مبتلایان روزانه رو به افزایش است، باید تلاش کنیم، بیماری را مهار و از پیک ششم نیز با سربلندی عبور نماییم.
معاون فنی مرکز بهداشت استان کرمانشاه گفت: خانوادهها برای تزریق واکسن کرونا به کودکان ۹ تا ۱۲ ساله خود تردید نداشته باشند و در اسرع وقت اقدام کنند.
معاون بهداشت دانشگاه علومپزشکی کرمانشاه:

معاون بهداشت دانشگاه علومپزشکی کرمانشاه گفت: کنترل و پیشگیری از سرطان یک ضرورت بهداشتی به شمار می رود، امسال هشتم لغایت پانزدهم بهمن ماه به عنوان هفته پویش ملی مبارزه با سرطان و با شعار" فاصله ها را کم کنیم" در نظر گرفته شده است.
معاون بهداشتی دانشگاه علوم پزشکی کرمانشاه در گفتگو با تابناک:

معاون بهداشتی دانشگاه علوم پزشکی کرمانشاه از آغاز موج ششم کرونا در کرمانشاه خبر داد و گفت: تنها راه مقابله با موج ششم واکسیناسیون و رعایت شیوه نامههای بهداشتی است.
سخنگوی ستاد مدیریت کرونا دانشگاه علومپزشکی کرمانشاه در گفتگو با تابناک:

سخنگوی ستاد مدیریت کرونا دانشگاه علومپزشکی کرمانشاه گفت: در رنگبندی جدید اعلام شده وضعیت شهر کرمانشاه زرد اعلام شد.
سخنگوی ستاد مدیریت کرونا کرمانشاه در گفتگو با تابناک:

سخنگوی ستاد مدیریت کرونا دانشگاه علوم پزشکی کرمانشاه گفت: خوشبختانه در شبانه روز گذشته هیچ موردی از فوت در کرمانشاه بر اثر کرونا گزارش نشده است.
سخنگوی ستاد مدیریت کرونا کرمانشاه در گفتگو با تابناک:

سخنگوی ستاد مدیریت کرونا دانشگاه علوم پزشکی کرمانشاه گفت: متاسفانه در شبانه روز گذشته یک مورد فوت در کرمانشاه بر اثر کرونا گزارش شده است.
رییس دانشگاه علوم پزشکی کرمانشاه:
رییس دانشگاه علوم پزشکی کرمانشاه، میزان واکسیناسیون نوبت اول کرونا در استان را ۹۰ درصد اعلام کرد و گفت: ۷۸/۶ درصد هم تاکنون دُز دوم واکسن خود را دریافت کردهاند.
سخنگوی ستاد مدیریت کرونا کرمانشاه در گفتگو با تابناک:

سخنگوی ستاد مدیریت کرونا دانشگاه علوم پزشکی کرمانشاه گفت: در شبانه روز گذشته موردی از فوت در کرمانشاه بر اثر کرونا گزارش نشده است.
مدیرکل پزشکی قانونی استان کرمانشاه از فوت ۱۷ نفر بر اثر برق گرفتگی در استان در نه ماهه امسال خبر داد.